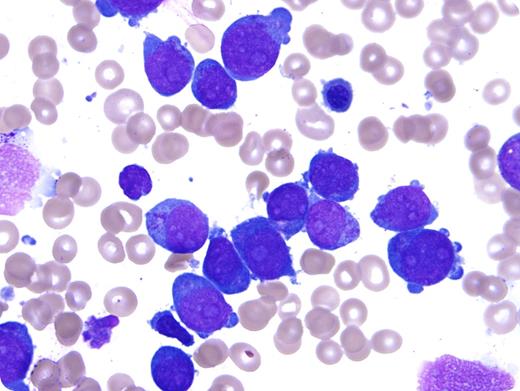
A 2-year-old girl with Down syndrome (DS) presented to the emergency department after developing easy bruising and a petechial rash on her arms, legs, and face. Her laboratory results on admission were significant for anemia and thrombocytopenia: white blood cells, 10.1 × 109/L; hemoglobin, 6.6 g/dL; hematocrit, 19.4%; mean corpuscular volume, 102.6 fL; red cell distribution width, 15.7%; and platelets, 3 × 109/L. Bone marrow aspirate smears (original magnification ×1000; Wright-Giemsa stain) revealed numerous large blasts with prominent nucleoli, deeply basophilic cytoplasm, coarse cytoplasmic granules, and frequent cytoplasmic blebbing. Flow cytometry showed that the blasts were positive for CD4, CD7, CD11b, CD13, CD33, CD34 (subset), CD36, CD38, CD45, and CD117, and negative for CD19, CD56, CD61, CD64, and HLA-DR. An immunohistochemical stain for CD31 was positive. The findings are diagnostic of myeloid leukemia associated with DS (ML-DS). / The megakaryoblastic morphology illustrated by this case is common in ML-DS. Most are positive for CD61, but some (like this case) lack CD61 while expressing other megakaryocytic markers, including CD31, CD41, and CD42b (the latter 2 were not tested in this case). Coarse cytoplasmic granules are often present in megakaryoblastic ML-DS, but are negative for myeloperoxidase and nonspecific esterase. Truncating somatic mutations of GATA1 are present in all ML-DS.

A 2-year-old girl with Down syndrome (DS) presented to the emergency department after developing easy bruising and a petechial rash on her arms, legs, and face. Her laboratory results on admission were significant for anemia and thrombocytopenia: white blood cells, 10.1 × 109/L; hemoglobin, 6.6 g/dL; hematocrit, 19.4%; mean corpuscular volume, 102.6 fL; red cell distribution width, 15.7%; and platelets, 3 × 109/L. Bone marrow aspirate smears (original magnification ×1000; Wright-Giemsa stain) revealed numerous large blasts with prominent nucleoli, deeply basophilic cytoplasm, coarse cytoplasmic granules, and frequent cytoplasmic blebbing. Flow cytometry showed that the blasts were positive for CD4, CD7, CD11b, CD13, CD33, CD34 (subset), CD36, CD38, CD45, and CD117, and negative for CD19, CD56, CD61, CD64, and HLA-DR. An immunohistochemical stain for CD31 was positive. The findings are diagnostic of myeloid leukemia associated with DS (ML-DS).
The megakaryoblastic morphology illustrated by this case is common in ML-DS. Most are positive for CD61, but some (like this case) lack CD61 while expressing other megakaryocytic markers, including CD31, CD41, and CD42b (the latter 2 were not tested in this case). Coarse cytoplasmic granules are often present in megakaryoblastic ML-DS, but are negative for myeloperoxidase and nonspecific esterase. Truncating somatic mutations of GATA1 are present in all ML-DS.
A 2-year-old girl with Down syndrome (DS) presented to the emergency department after developing easy bruising and a petechial rash on her arms, legs, and face. Her laboratory results on admission were significant for anemia and thrombocytopenia: white blood cells, 10.1 × 109/L; hemoglobin, 6.6 g/dL; hematocrit, 19.4%; mean corpuscular volume, 102.6 fL; red cell distribution width, 15.7%; and platelets, 3 × 109/L. Bone marrow aspirate smears (original magnification ×1000; Wright-Giemsa stain) revealed numerous large blasts with prominent nucleoli, deeply basophilic cytoplasm, coarse cytoplasmic granules, and frequent cytoplasmic blebbing. Flow cytometry showed that the blasts were positive for CD4, CD7, CD11b, CD13, CD33, CD34 (subset), CD36, CD38, CD45, and CD117, and negative for CD19, CD56, CD61, CD64, and HLA-DR. An immunohistochemical stain for CD31 was positive. The findings are diagnostic of myeloid leukemia associated with DS (ML-DS).
The megakaryoblastic morphology illustrated by this case is common in ML-DS. Most are positive for CD61, but some (like this case) lack CD61 while expressing other megakaryocytic markers, including CD31, CD41, and CD42b (the latter 2 were not tested in this case). Coarse cytoplasmic granules are often present in megakaryoblastic ML-DS, but are negative for myeloperoxidase and nonspecific esterase. Truncating somatic mutations of GATA1 are present in all ML-DS.
For additional images, visit the ASH IMAGE BANK, a reference and teaching tool that is continually updated with new atlas and case study images. For more information visit http://imagebank.hematology.org.